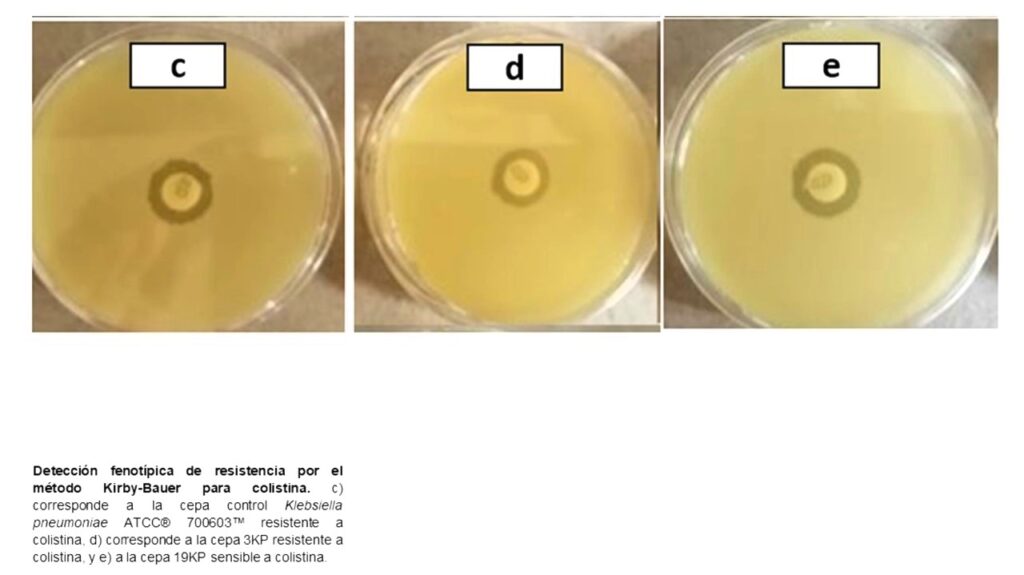

Señalan que cepas bacterianas son resistentes al antibiótico colistina que se utiliza para combatir microorganismos.
Ante la resistencia al antibiotico denominada colistina, de algunas bacterias que pululan en hospitales, cientificos del Instituto Politécnico Nacional (IPN) proponen al sistema de salud nuevos tratamientos combinados con antibióticos.
Lo anterior, luego de un estudio que realizaron los científicos del IPN sobre cepas bacterianas en hospitales, donde detectaron que algunas de ellas son resistentes al antibiótico denominado colistina, utilizado para combatir microorganismos multirresistentes.
Al respecto, la experta en bacteriología de la Escuela Nacional de Ciencias Biológicas (ENCB), Graciela Castro Escarpulli, aseguró que los avances obtenidos de este estudio se deben al uso de la técnica de edición genética denominada Grupo de Repetidos Palindrómicos Cortos Regularmente Intercalados (CRISPR-Cas por sus siglas en inglés).

Indicó que se empleó un modelo de tipificación bacteriana para determinar la sensibilidad, resistencia y nivel de virulencia de los microorganismos a partir de un punto de corte o edición. “Este estudio permitirá proponer a los hospitales, terapias combinadas a base de dos o más antibióticos a los que no sean resistentes las bacterias en cuestión”.
La integrante del Sistema Nacional de Investigadores (SNI) Nivel I detalló que a lo largo de su trayectoria como científica ha conformado una colección de 128 cepas de la bacteria Aeromonas, las cuales secuenció con el apoyo de su grupo de trabajo y colaboradores del extranjero.
“Esta colección fue transcendental para encontrar que varias de ellas son resistentes a la colistina (antibiótico de última generación), así como otros grupos bacterianos (Klebsiella pneumoniae y Pseudomonas aeruginosa) que también presentaron resistencia al mismo”.
La doctora Castro Escarpulli cuenta con diversas publicaciones en revistas científicas arbitradas sobre esta línea de investigación, en la que colaboran especialistas en pediatría del Centro Médico Nacional “Siglo XXI”, de los Hospitales Infantil de México “Federico Gómez” y “Juárez de México”, además de científicos de universidades de Inglaterra y España, quienes al lado de un grupo de estudiantes de posgrado de la ENCB hacen ciencia de frontera y actualmente detectan genes (mcr), relacionados con la resistencia a la colistina.
Fotos: IPN

